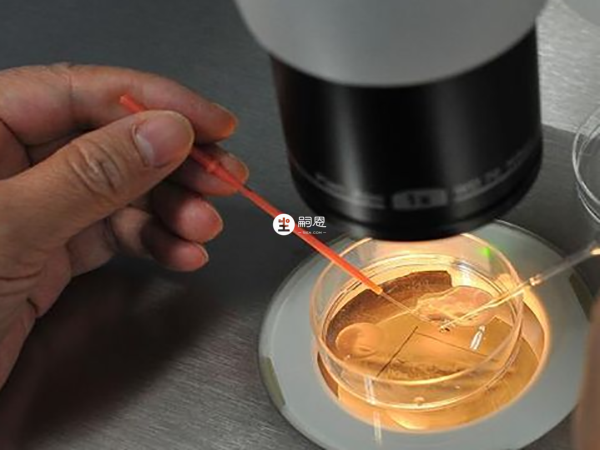

章明基

男方患有少弱精证症等疾病,精子出问题无法正常生育,这种家庭可以通过供精人工授精怀上孩子。有的夫妻双方做供精前商量好了,但过程中往往会出现一些新的波折,供精生子的家庭都怎么样了?供精生下孩子的家庭,日后生活又到底会有什么问题。

供精孩子家庭会不会幸福还是要结合实际情况判断,但大多数情况下,这部分人家庭过的还是不错的,有很多夫妇因为不孕不育症无法实现生育梦想,而通过供精能实现他们的梦想,所以大部分的家庭在孩子出生后都非常幸福和睦。
但做供精试管也是会存在弊端的,也有些家庭选择供精后反而导致婚姻破裂,这都是无法确定的,但其原因更多的是家庭沟通出现了问题,夫妻双方不能相互理解导致的,一般不止是孩子身份。
一般选择供精的家庭都是男方精子出现了问题,如严重的少弱精症,或因精子问题母体和胎儿血型不合,从法律上来讲,供精生下的孩子,男方也是唯一的合法父亲,并没有什么特殊之处,但确实也有部分供精家庭容易产生矛盾,以下为大家收集了一些供精家庭的现状,可供参考:
脆皮夹心
桃红玫瑰
桃红玫瑰
现如今,无精症男性可通过供精人授或试管获得与妻子有血缘关系的孩子,但这样一来可能面临的问题会不少,常见的如家庭纠纷、孩子心里为题、健康问题等。除此之外,还归纳了大众讨论度比较高的话题,感兴趣的姐妹可点击前往了解:
5、供精孩子家庭会不会幸福
四代试管
卵巢早衰交流群三代试管
优生优育攻略群高龄生子
绝经助孕攻略群无精/死精
显微取精交流群冷冻卵子
生育力保存经验群出国生子
海外试管交流群大家在看